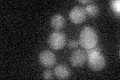
YBR210W
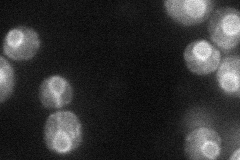
YBR210W
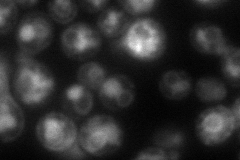
YBR210W
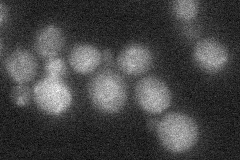
YBR210W
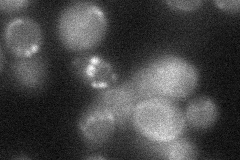
YBR210W

View description
Protein involved in export of proteins from the endoplasmic reticulum, has similarity to Erv14p
Localization:
Intensity:
Fold change:
Significance:
-
C’ GFP library in SD
cytosol18.64 -
N' NOP1pr-GFP in SD
ER43.2004 -
N' TEF2pr-mCherry in SD
ER,vacuole65.4405 -
N' NATIVEpr-GFP in SD
below threshold15.0013 -
N' TEF2pr-VC and Cyto-VN in SD
below threshold24.5632 -
C’ GFP library in SD+DTT

cytosol19.131.02No -
C’ GFP library in SD+H2O2

cytosol15.140.81No -
C’ GFP library in Starvation Media

cytosol17.840.95No -
C’ GFP library on the background of Pup2-DaMP

cytosol -
C’ GFP library on the background of CCT mutant

cytosol15.87380.8513No
